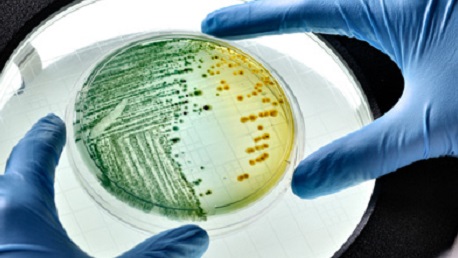

CUOA – Il master in Biotech per le imprese
Il CUOA Business School amplia la sua offerta formativa executive e dà il via alla prima edizione dell’Executive Master in Biotech per le Imprese (EMIB), in partenza il 13 novembre prossimo.
Realizzato con il patrocinio di Federchimica Assobiotec e con il Dipartimento di Scienze Biomediche del Consiglio Nazionale delle Ricerche, il percorso part time mira a formare i manager che operano in settori determinanti per lo sviluppo delle imprese in campo biotecnologico, in relazione alle dimensioni economiche, finanziarie e patrimoniali, quali: l’agroindustria, la farmaceutica e la diagnostica e la green economy.
“Abbiamo deciso di introdurre questo master all’interno della nostra offerta formativa part time destinata agli executive – spiega Alfonsa Martelli, Coordinatore scientifico del Master – sulla scia della positiva esperienza avuta con un percorso molto simile, il BIOTEMA – Master in Biotecnologie per l’Impresa che, tuttavia, era indirizzato a un target più giovane. Con questo corso executive, invece, vogliamo fornire risposta alle emergenti e forti esigenze dei professionisti del settore, con tre differenti specializzazioni: Green Economy, Agroalimentare e Agroindustriale e, infine, Chimico-Farmaceutico e Diagnostico. Il percorso nasce dal bisogno, rilevato come prioritario, di integrare le competenze tecniche con spiccate capacità manageriali e gestionali”.
L’Executive Master in Biotech per le Imprese fornirà competenze manageriali in grado di far evolvere le figure tecniche in veri e propri gestori del business, orientai all’applicazione delle conoscenze biotecnologiche per i fini produttivi e di redditività delle imprese.
Il percorso avrà una durata totale di 310 ore e prevedrà lezioni frontali, progettazione di prodotti innovativi attraverso lo sviluppo di business plan, analisi di settore specialistico, attività di counseling individuale, manageriale e imprenditoriale nel settore biotech.
Si inizierà con 130 ore di Corso Executive in Biotecnologie e Management (composto da una parte Manageriale, una Scientifica e un Business Plan finale), per poi proseguire con un Modulo Specialistico di 80 ore (a scelta tra le 3 specializzazioni) Seguiranno 100 ore di Action Learning (project work individuale) e 3 incontri di counselling individuale per lo Sviluppo delle abilità personali (della durata di 1 ora ciascuno).
I percorsi specialistici CUOA in formula part time sono pensati per quanti vogliono sviluppare competenze specifiche di immediata applicabilità al proprio contesto lavorativo, hanno un taglio fortemente pratico e operativo e offrono un importante bagaglio di conoscenze e competenze manageriali, utili a 360° per il proprio sviluppo di carriera.